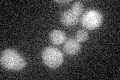
YGL258W
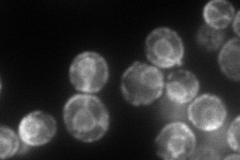
YGL258W

View description
Protein of unknown function; highly induced in zinc-depleted conditions and has increased expression in NAP1 deletion mutants
Localization:
Intensity:
Fold change:
Significance:
-
C’ GFP library in SD
below threshold16.82 -
N' NOP1pr-GFP in SD
cell periphery,ER156.689 -
N' TEF2pr-mCherry in SD

ER,vacuole29.919 -
N' NATIVEpr-GFP in SD

below threshold21.0381 -
N' TEF2pr-VC and Cyto-VN in SD

#N/A0 -
C’ GFP library in SD+DTT

cytosol16.830.99No -
C’ GFP library in SD+H2O2

cytosol14.940.88No -
C’ GFP library in Starvation Media

cytosol15.580.92No -
C’ GFP library on the background of Pup2-DaMP

below threshold -
C’ GFP library on the background of CCT mutant

below threshold20.10121.19392No
